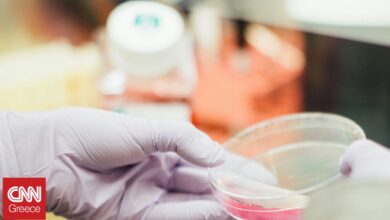

Η ρωσική πρεσβεία στη Δαμασκό καλεί τους Ρώσους να φύγουν από τη Συρία

Η πρεσβεία της Ρωσίας στη Συρία κάλεσε τους Ρώσους πολίτες να φύγουν από η χώρα με εμπορικές πτήσεις, μετά την επίθεση που εξαπέλυσαν αντάρτες εναντίον του συριακού στρατού, όπως μετέδωσε το κρατικό πρακτορείο ειδήσεων της Ρωσίας TASS.
Νωρίτερα ο υπουργός Εξωτερικών Σεργκέι Λαβρόφ έστειλε μέσω τη συνέντευξης που έδωσε στον Αμερικανό δημοσιογράφο Τάκερ Κάρλσον, ξεκάθαρο μήνυμα στη Δύση και τις ΗΠΑ ότι η Μόσχα θα χρησιμοποιήσει κάθε μέσο για να αποτρέψει την στρατηγική ήττα της Ρωσίας στην οποία αποσκοπεί η Δύση.
«Το μήνυμα είναι ότι εσείς, εννοώ οι ΗΠΑ και οι σύμμαχοι των ΗΠΑ, που επίσης παρέχουν αυτά τα όπλα μεγάλου βεληνεκούς στο καθεστώς του Κιέβου – πρέπει να καταλάβουν ότι θα είμαστε έτοιμοι να χρησιμοποιήσουμε κάθε μέσο για να μην τους επιτρέψουμε να πετύχουν αυτό που αποκαλούν στρατηγική ήττα της Ρωσίας», δήλωσε χαρακτηριστικά ο Λαβρόφ.
«Αγωνίζονται για τη διατήρηση της ηγεμονίας τους στον κόσμο, σε οποιαδήποτε χώρα, οποιαδήποτε περιοχή, οποιαδήποτε ήπειρο. Εμείς αγωνιζόμαστε για τα νόμιμα συμφέροντα ασφαλείας μας», πρόσθεσε.